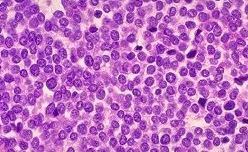

El signo de la tecla de piano es característico de qué luxación?
Luxación acromio-clavicular
Paciente de 15 años que presenta dolor y tumefacción en pierna izquierda, de dos meses de evolución, sin antecedentes traumáticos ni de otro tipo. Radiológicamente se observa reacción perióstica que afecta a la práctica totalidad de la diáfisis del peroné en forma de capas de cebolla, así como espículas radiadas a partir del córtex óseo en forma de púas de peine.
Sarcoma Ewing
características histológicas sarcoma ewing
Células de pequeño tamaño de forma redondeada con núcleos de gran tamaño y citoplasma escaso
Es CD 95 + en más del 95% de los casos.
El mecanismo típico de la lesión del LCA
Valgo y rotación interna

Tendón rotuliano ( tuberosidad tibial anterior )
Durante el crecimiento es frecuente la aparición de una entesitis, o inflamación en el lugar de inserción del tendón rotuliano, que se conoce con el nombre de enfermedad de Osgood Schlatter
Colágeno presente en el hueso es de tipo
I
I : En la dermis, tendones, ligamentos, HUESO y dentina y tiene función de resistencia.
II : En el CARTILAGO hialino y elástico con función de restiencia.
III : En el sistema linfático, hígado, sistema cardiovascular, pulmones y piel, con función estructural.
IV : En la lámina basal con función de soporte
V : En la dermis, tendones, y ligamentos
Parestesias en los tres primeros dedos de la mano, empeoramiento nocturno, aumento con la compresión a nivel de la región palmar proximal
Compresión del nervio mediano a nivel del túnel carpiano
Tto: conservador primero con férula nocturna, infiltraciones. Si fracasa se realiza la descompresión del nervio mediano
Fractura subcapital desplazada en paciente menor de 65 años
Reducción cerrada y osteosíntesis con tornillos canulados
Si 65-75: prótesis total
>75 a: prótesis parcial
Aumento del tamaño en pocos meses de una masa descubierta hace 15 años. En la radiografía simple se aprecia una masa sesil que nace de la región posterior del fémur de unos 5 cm de diámetro, irregular, con calcificaciones dispersas
Condrosarcoma ( osteocondroma que ha malignizado )
Luxación acromiocalvicular:
- Grado I: dolor local
- Grado II: lesión ligamentos coracoclaviculares con inestabilidad horizontal
- Grado III: lesión ligamentos coracoclaviculares y acromioclaviculares con inestabilidad horizontal y vertical.
Paciente de 23 años con un esguince grave inmovilizado con una férula suropédica que 10 días después acude a Urgencias por molestias con la férula. Presenta dolor que cede parcialmente con analgesia de primer escalón y aumento de volumen de la pierna muslo
Debemos descartar la presencia de una trombosis venosa profunda mediante un ECO-Doppler venoso de miembro inferior
Qué musculo innerva el nervio circunflejo
Deltoides

Qué innervan:
- Bíceps braquial y braquial anterior:
- Trapecio y esternocleidomastoideo
- Cuádriceps y psoas:
- Adductores (muslo):
- Semitendinoso/Semimembranoso, Gemelos/Sóleo:
- Supraespinoso:
- musculocutáneo
- n. espinal (XI par)
- femoral
- obturador
- tibial
- supraescapular
Tto fracturas segun localización
RAFI:
Metafisis o intraarticular ( reducción anatómica )
Placas, tornillos, cerclaje
RCFI:
Diafisis huesos largos
Clavos
OS percutánea:
Fx mano / infantiles
FE:
Politrauma
Abiertas ( IIIB, IIIC )
Clasificación fracturas abiertas GUSTILLO

Complicaciones fracturas

Tto fracturas

Indicaciones tto quirúrgico fractura
Fracaso tto conservador
Intraarticular >2 mm
Fr luxación
Art. flotante
Inestable
BL
Fx abierta
Politrauma
Sd compartimental
L. Neurovascular
Fx patológica ( neo )
Escala que valora la amputación
Escala MESS
( edad, el estado vascular del miembro afectado, la estabilidad hemodinámica, el periodo de tiempo transcurrido desde el accidente y la energía del traumatismo inicial )

Fractura supracondílea
( caída en extensión )
Posibilidad de complicaciones vasculares, nerviosas o sd compartimental
Niño de talla baja con cojera y dolor UL que no puede hacer rotación ni abducción

Enf. Perthes
De donde es tipica la fractura tipo II de Salter y Harris
Radio distal
De donde es tipica la fractura tipo III de Salter y Harris
Tibia distal
Lesión por tracción brusca en el brazo de un niño menor a 4 años
Subluxacion cabeza radial fuera del ligamento anular
Rx normal
Maniobra de supinación y flexión sin inmovilización posterior




































